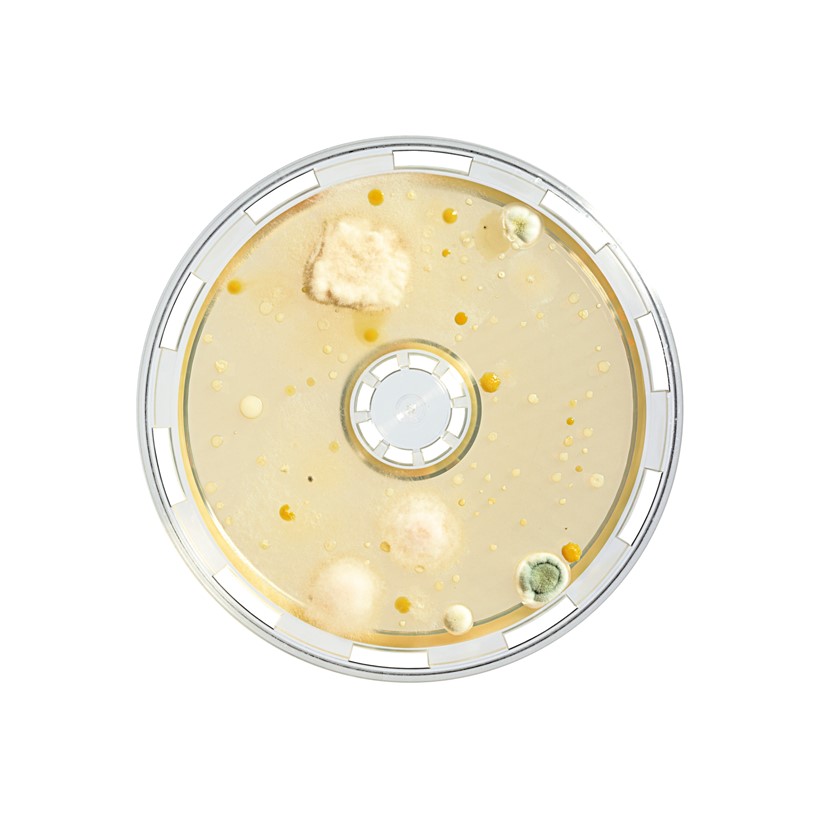

BACTair™ agar mediji koriste se za mikrobiološku kontrolu zraka s MD8 Airport uzorkivačem zraka ("impaction metodom"). Mikroorganizmi u zraku izravno se hvataju na podloge koje izravno djeluju kao glave za prikupljanje mikroorganizama. Metalna sita ili metalni sakupljači s utorima, koji se moraju sterilizirati za rutinsko uzorkovanje aerobnih mikroorganizama na redovnoj osnovi, postali su stvar prošlosti sa BACTair™ medijima.